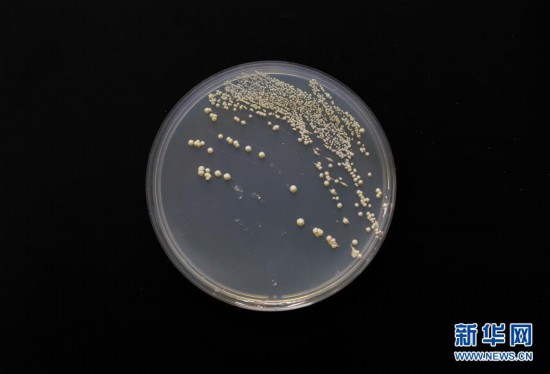
9791017330012574699.jpg

5年,对于一座城市意味着什么?
2014年5月,习近平总书记对上海作出建设具有全球影响力的科技创新中心的重要指示。
从量子密钥分发系统的安全距离扩展至200公里,到墨子号量子科学实验卫星发射升空;从首架C919大型客机一飞冲天,到实现克隆猴“中中”“华华”呱呱坠地……5年间,一批标志性原创成果竞相涌现,一批世界级科技设施迅速集聚,上海开放型创新生态加快形成,科技创新中心建设取得重要的阶段性成果。
聚焦“最先一公里”“最后一公里”提升创新“策源力”
4月10日,人类首张黑洞照片在上海天文台等全球多地发布。
在科技创新的广袤和无垠里,这样的“上海时刻”频频亮相:

C919大型客机在上海浦东机场起飞(2018年7月12日摄)。 新华社记者 丁汀 摄
——蛟龙、天宫、北斗、天眼、墨子和大飞机等多项重大科技成果,上海都作出了重要贡献,仅中科院在沪单位就有超过2000名科研人员参与;
——2014至2018年,中国每年的10大科学进展,上海原创成果从未缺席。5年50项重大进展,上海牵头或参与11项;

五只生物节律紊乱体细胞克隆猴(2018年11月27日摄)。中国科学院神经科学研究所的孙强研究员与刘真研究员、张洪钧研究员合作,三个研究团队经过三年努力,利用基因编辑技术(CRISPR/Cas9),成功构建了世界首例核心节律基因BMAL1敲除猕猴模型。 新华社发(中科院神经科学研究所供图)
——2017年超强超短激光装置实现10拍瓦激光放大输出,2018年上海诞生国际首个体细胞克隆猴、国际首次人工创建单条染色体的真核细胞。
全球科创中心建设没有捷径。瞄准全球前沿、补短板拉长板,上海将重点放在了基础科研的原始创新、关键核心“卡脖子”技术两大主攻方向。
筑牢“最先一公里”地基。以强化原始创新为目标,上海着力提升创新策源力,2018年上海科学家在国际权威期刊《科学》《自然》《细胞》上发表原创论文85篇,占全国总量的32.2%。
今年5月初,落户上海张江国家科学中心的大科学装置上海光源度过10岁生日,2.5万个世界各地的用户借助“上海之光”产生了一批世界级科研成果。大科学装置完成从“单兵作战”向“集群发力”转型,全球规模最大、种类最全、功能最强的世界级光子科学中心,在张江蓄势成形。
广拓“最后一公里”空间。聚焦集成电路、人工智能、生物医药等三大关键领域,围绕关键核心技术和“卡脖子”领域,创新的种子在这里发芽、壮大。

在上海国际会议中心举行的发布会上,寒武纪科技公司首席执行官陈天石介绍新发布的国内首款云端人工智能芯片(2018年5月3日摄)。 新华社记者 金立旺 摄
上海“芯”创造澎湃新动能:中微半导体适用于最先进制程的集成电路制造装备刻蚀机、寒武纪科技的云端AI芯片……这里成为国内集成电路产业链最完善、产业集中度最高、综合技术能力最强的地区之一;
上海“智”蓄势高质量发展:在徐汇的人工智能大厦、AI小镇,浦东的人工智能岛,杨浦的国家双创示范基地等集聚区,BAT、小米、商汤科技、依图科技等巨头汇聚发展,为高质量发展赋能;
上海“药”跻身全球领先高地:阿尔茨海默症,人类至今未能攻克的疾病难题,连续16年全球无一款该领域新药上市。如今上海科研院所牵头的国际首个抗阿尔茨海默症糖类新药已完成临床试验。
目前,上海全社会研发投入占GDP比例达4%,比5年前提升0.35个百分点;每万人口发明专利拥有量达到47.5件,比5年前翻了一倍;平均每个工作日新注册企业达1332家,活跃度达到80%以上。
在中科院分子植物卓越中心/植生生态所合成生物学重点实验室内拍摄的单条染色体真核酵母(2018年7月31日摄)。 新华社记者 丁汀 摄
以深化改革点燃创新“新引擎”
制度创新是支撑科创中心建设的“牛鼻子”。上海着力破除制约创新发展的机制障碍,“放”体制、聚人才、谋布局、优环境。
体制机制上,核心是“放”,“我的科研我做主”。上海市科委主任张全说,在推进科技体制地方配套改革中,上海已发布超过70个地方配套政策,涉及170多项改革举措。2019年又发布了科改“25条”,并将科创中心建设条例列入了年度立法计划……

覃重军团队及学生在中科院分子植物卓越中心/植生生态所合成生物学重点实验室内(2018年7月31日摄)。新华社记者 丁汀 摄
人才政策上,关键是“聚”,“量身定制,一人一策”。上海先后出台“人才20条”“人才30条”“人才高峰工程行动方案”,聚焦上海有基础、有优势、能突破的重点领域,精准施策,让有作为、有贡献的科研人员“名利双收”。
前瞻布局上,重点是“谋”,“把握创新主战场”。上海市经信委主任吴金城说,按照市委市政府部署,上海产业转型坚持“有所为有所不为”,突出重点,加快建设规模体量大、成长性高、引领性强的战略性新兴产业集群。“在集成电路、人工智能、生物医药等三大重点领域,全力以赴、做大做强。”
营商环境上,抓手在“优”,“对标最高最好”。上海泰坦科技专注于提供高端实验室整体解决方案,启动时就得益于科创基金的扶持,如今已成长为科技服务行业的“隐形冠军”。创始人谢应波说,在消费互联网向产业互联网转变过程中,上海的精细化服务能力、健全的产业门类,使得这里有机会诞生新的科技创新企业巨头。设立科创板如同及时雨,将松绑大量“隐形冠军”的创新压力,让金融中心和科创中心形成良性互动。
上海自贸区新片区、科创板、长三角一体化以及中国国际进口博览会,共同构成了上海在更高起点、更高层次上推进改革开放的战略支撑。上海市副市长吴清说,科创中心建设,将继续坚持面向全球、面向未来,结合这些重大任务,联动发展,在增强创新策源能力上下更大功夫。

工作人员在2018世界人工智能大会现场演示与机器人打乒乓球(2018年9月17日摄)。 新华社记者 丁汀 摄
以开放协同打造创新“强磁场”
作为我国对外开放的高地,上海是外资研发中心集聚度最高的地方,占据全国总量1/4的外资研发队伍,成为激活创新的重要力量。
“2018年,对我们来说,最重要的选择就是第一次走出去,在上海成立分院。”微软亚洲研究院院长洪小文说,上海对科技营商环境生态的重视,让微软将这里作为人工智能战略布局的重要阵地。如今,微软亚洲研究院(上海)和微软-仪电人工智能创新院均已在徐汇落户。
筹划在更大范围、更高层级的国际合作,上海已设立了5个“一带一路”沿线国家(地区)技术转移中心,开展中俄战略科技合作,启动建设普陀中以(上海)创新园……
开放式创新,不但要对外开放,也要对内开放,让创新的“朋友圈”可以在更大范围内集聚、配置创新资源和要素。

在中科院分子植物卓越中心/植生生态所内,覃重军团队成员在电子显微镜前观察单条染色体真核细胞形态(2018年7月31日摄)。 新华社记者 丁汀 摄
伴随着长三角区域一体化发展上升为国家战略,长三角地区协同科技创新正按下“加速键”。推进总价值超300亿元的大型科学仪器设施开放共享,长三角产业地图呼之欲出……最新数据显示,申报本年度上海技术发明奖、科技进步奖高等级奖项并最终脱颖而出的项目中,约30%都带有长三角协同创新的印记。
政府搭台,市场主导,企业唱戏。从松江G60科创走廊、漕河泾知识产权示范区等多层次功能承载区,到世界人工智能大会、滴水湖论坛等顶尖论坛,持续发挥引领辐射带动作用,上海正打造集聚全球创新资源的“强磁场”、创新成果的“原产地”。
上海市委有关方面介绍说,站上新的台阶,上海将以更大的决心和力度,抓住关键领域、重大课题,聚力突破、加速前进,紧紧围绕形成符合科技创新规律的资源配置方式这个关键,把各方面创新要素的活力充分激发出来,形成科创中心建设“满盘皆活”的生动局面。(新华社上海5月19日电 记者 姜微 周琳 王琳琳)
免责声明:转载此文目的在于传递更多信息,请读者仅作参考,并请自行核实相关内容。不代表本平台的观点和立场。市场有风险,选择需谨慎!此文仅供参考,不构成购买及投资建议,不作买卖依据。投资者据此操作,风险自担!